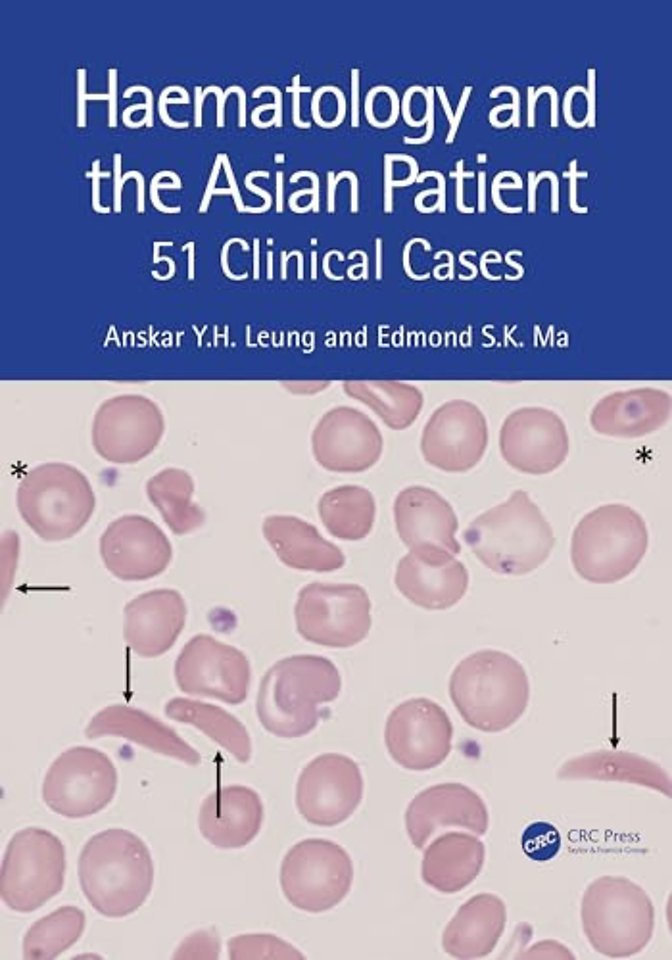
Haematology and the Asian Patient
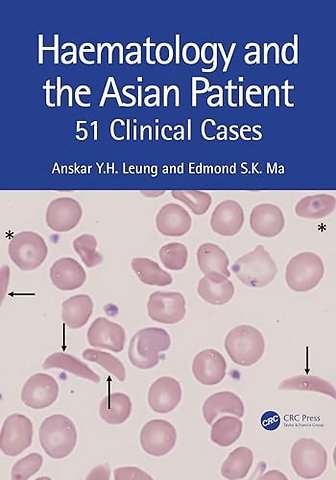
Haematology and the Asian Patient

Haematology and the Asian Patient
51 Clinical Cases
Samenvatting
It aims to highlight the pathophysiology, clinical presentations and basic principles in the investigations and managements of haematological diseases prevalent in Asia. Each chapter begins with a real-case clinical scenario, followed by a set of questions and is complemented by photomicrographs, data charts and illustrations.